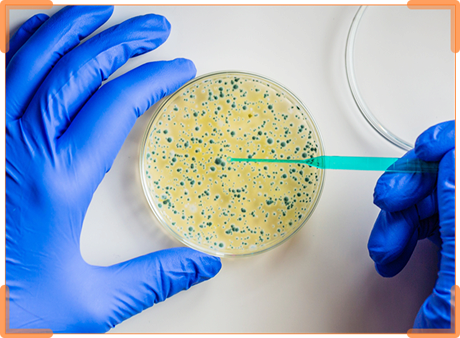

AVer U50+
USB Visualizer (Dokumentenkamera)

USB Visualizer (Dokumentenkamera)
Vorstellung der U50+ Visualizer — ein einzigartiges Gerät für effizientes Unterrichten. Mit seiner beeindruckenden reibungslosen 60-fps-Bildgebung und einer 8-Megapixel-Linse erfasst die U50+ alle Details mit höchster Auflösung. Dank des praktischen Griffs lässt sie sich überall hin mitnehmen und ganz einfach verstauen. Die dazugehörige AVerTouch-Software sorgt für hochwertige Bilderfassung, Aufzeichnung in Echtzeit und Upload in die Cloud über Google Classroom, für interaktives und reflexives Lernen.
Premium-Kamera, die Zukunft der Bildgebung
Die hochlauflösende Kamera der U50+ mit bis zu 8 Megapixel Auflösung und das 16-fach digitale Zoomobjektiv ermöglicht Lehrkräften die Präsentation von Realien in herausragender Klarheit. Nun erfassen die Lernenden jedes noch so kleine Detail – Lernen in einer völlig neuen Dimension.
USB Plug-and-Play
Die U50+ benötigt lediglich ein einziges USB-Kabel für Strom und Konnektivität. Dieses einfache Setup erlaubt Lehrkräften den Unterricht zu jeder Zeit und von überall aus. Die U50+ ist das unverzichtbare Tool für Fernunterricht und hybride Klassenzimmer.
Tragbares Design
Das U50 + ist für den einfachen Transport ausgelegt. Dank des integrierten Griffs lässt sich die U50+ ganz einfach tragen. Der passgenaue Rahmen des Kamerakopfs und ein flexibles Armdesign stellen sicher, dass die U50+ geschützt ist, wenn sie mit Ihren anderen Lernhilfen gemeinsam transportiert wird.


Eine Kamera für mehrere Winkel und Funktionen
Die U50+ ist sowohl ein Visualizer (Dokumentenkamera) als auch eine Webcam Der flexible Arm lässt sich in jeden gewünschten Winkel biegen, so dass Lehrkräfte ihre Lehrmaterialen stets exakt präsentieren können. Ohne Präsentationsmaterial lässt sich die U50+ als Webcam nutzen; zusätzliche Geräte für den Unterricht sind nicht erforderlich.













